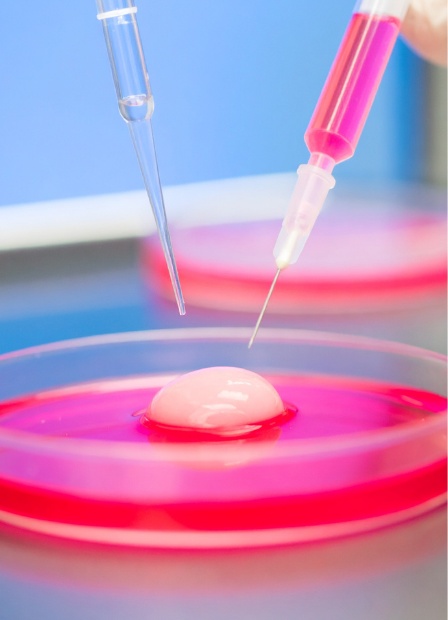
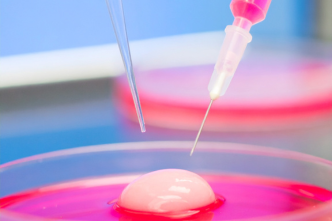

Why Choose Laser-Assisted Hatching at ARC?
Enhance your IVF success with precisionnLaser-Assisted Hatching, designed to support stronger embryo implantation and improve pregnancy outcomes.
- Enhanced Implantation Chances – Helps embryos attach more effectively to the uterine lining
- Advanced Laser Precision – Safe, controlled technique using state-of-the-art laser equipment
- Ideal for Specific IVF Challenges – Especially beneficial for older women or those with previous IVF failures
- IVF Excellence Award
- Patient-Centered
- 25+ Years IVF Expertise
Start Your Journey Today
Get expert consultation from our fertility specialists
- Trusted by 1,00,000+ Couples
Understanding Laser-Assisted Hatching Treatment
Get comprehensive information about Laser-Assisted Hatching to make informed decisions about your fertility journey
What is Laser-Assisted Hatching?
Understanding the Embryo Hatching Enhancement Technique
Laser-Assisted Hatching is an advanced micromanipulation technique used during IVF. It involves creating a tiny opening in the embryo’s outer shell (zona pellucida) using a precise laser to help the embryo hatch and implant more easily in the uterus.
- Some embryos may struggle to hatch naturally due to a thicker zona
- A laser beam is used to gently thin or open the zona pellucida
- This is performed just before the embryo transfer
- It does not damage the embryo and is done under strict lab conditions
- It improves chances of implantation, especially in certain high-risk groups

When to Choose Laser-Assisted Hatching?
Right time for Laser Hatching in IVF treatment
This technique is usually recommended when certain biological or clinical factors may reduce natural embryo hatching.
- Women aged 35 and above
- Embryos with a thick or hardened zona pellucida
- Couples with previous failed IVF or ICSI cycles
- Patients using frozen embryos (FET)
- Couples undergoing Preimplantation Genetic Testing (PGT)


Who Can Prefer Laser-Assisted Hatching?
Ideal candidates for laser hatching procedure
Laser-Assisted Hatching is suited for individuals who face implantation difficulties due to age, embryo shell quality, or prior IVF failures.
- Women with age-related fertility decline
- Couples with multiple unsuccessful embryo transfers
- Embryos that show slow development or thick outer shell
- Patients using donor eggs or embryos
- Those undergoing advanced IVF protocols with genetic screening


Ready to Start Your Laser-Assisted Hatching Journey?
Schedule a consultation with our fertility specialists to discuss your personalized treatment plan
Laser-Assisted Hatching Process at ARC
Our expert embryologists use precision laser tools to enhance embryo hatching and boost implantation success.
1
Embryo Development
- Days 1–3
Embryos are cultured and monitored after fertilization through IVF or ICSI.
2
Laser Hatching Procedure
- Day 3 or Day 5
A high-precision laser creates a small hole or thinning in the zona pellucida to help the embryo hatch.
3
Embryo Transfer
- Same day
The laser-treated embryo is gently transferred into the uterus using ultrasound guidance in a painless, outpatient procedure.
4
Pregnancy Test
- 2 weeks later
A blood test is done around 14 days after transfer to confirm pregnancy success.
Ready to Begin Your LAH Journey?
Our experienced fertility specialists will guide you through every step of the process with personalized care and support
Why Choose ARC for LAH
Leading fertility care with proven success and trusted expertise
Trusted by millions
Performed with Precision
Proven results
Backed by Expertise
Join Thousands of Successful Families
Experience the difference with ARC's personalized IVF treatment and compassionate care
Frequently Asked Questions
Get answers to the most common Laser Hatching questions
Is laser-assisted hatching safe for the embryo?
Yes, it is very safe when performed by skilled embryologists. ARC uses precise, non-contact lasers to gently thin or open the embryo’s outer shell without harming the embryo itself.
Does laser-assisted hatching improve implantation rates?
In select cases, yes. Especially for women with previous IVF failures, thick zona pellucida, or advanced age, laser hatching can help the embryo implant more successfully.
When is laser hatching performed in the IVF cycle?
It is typically done on Day 3 or Day 5 embryos, just before they are transferred to the uterus during an IVF cycle.
Is laser-assisted hatching included in all IVF cycles at ARC?
No, it's recommended based on individual clinical need. Your fertility specialist will decide if this technique will benefit your specific case.
Will laser hatching damage the embryo or affect the baby?
No. The procedure is highly controlled, and there is no evidence suggesting any negative impact on embryo development or the health of the baby.

